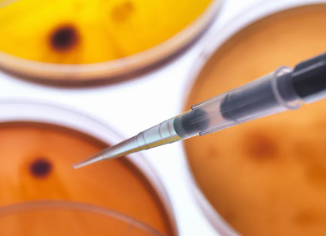
image.png

山東省齊魯干細(xì)胞收費(fèi)標(biāo)準(zhǔn)是怎樣的?如何了解具體價(jià)格信息?
2024-10-22 11:57:37 來源: 小編 咨詢醫(yī)生
本文將為您詳細(xì)介紹齊魯干細(xì)胞收費(fèi)的相關(guān)信息,以及如何獲取具體的價(jià)格詳情,幫助您對(duì)此有更加清晰的了解。
一、山東省齊魯干細(xì)胞簡(jiǎn)介
齊魯干細(xì)胞是一家專注于干細(xì)胞技術(shù)研發(fā)、應(yīng)用及產(chǎn)業(yè)化的高新技術(shù)企業(yè),位于山東省濟(jì)南市。公司依托先進(jìn)的科研技術(shù),致力于為我國干細(xì)胞研究及應(yīng)用提供高質(zhì)量的服務(wù)。其主要業(yè)務(wù)包括干細(xì)胞儲(chǔ)存、制備、研發(fā)等。
二、齊魯干細(xì)胞收費(fèi)標(biāo)準(zhǔn)
齊魯干細(xì)胞的收費(fèi)標(biāo)準(zhǔn)主要根據(jù)服務(wù)項(xiàng)目、儲(chǔ)存時(shí)間等因素來確定。以下為幾個(gè)常見的服務(wù)項(xiàng)目及大致價(jià)格范圍:
1.干細(xì)胞儲(chǔ)存:根據(jù)儲(chǔ)存年限不同,價(jià)格一般在幾千到幾萬元不等。儲(chǔ)存年限越長(zhǎng),費(fèi)用相**高。
2.干細(xì)胞制備:價(jià)格根據(jù)制備難度、數(shù)量等因素來確定,一般在幾千到幾萬元之間。
3.干細(xì)胞研發(fā):根據(jù)項(xiàng)目需求、研發(fā)難度等因素,價(jià)格在幾萬元到幾十萬元不等。
需要注意的是,具體價(jià)格可能會(huì)有所變動(dòng),請(qǐng)以實(shí)際情況為準(zhǔn)。
三、如何了解具體價(jià)格信息
1.官方網(wǎng)站:您可以通過訪問齊魯干細(xì)胞官方網(wǎng)站(網(wǎng)址:http://www.qilugsc.com/)了解具體價(jià)格信息。在網(wǎng)站首頁,您可以找到“收費(fèi)標(biāo)準(zhǔn)”或“價(jià)格表”等相關(guān)內(nèi)容,查看詳細(xì)的價(jià)格信息。
2.電話咨詢:如果您對(duì)網(wǎng)站上的信息仍有疑問,可以撥打齊魯干細(xì)胞官方電話(0531-82188180)進(jìn)行咨詢。工作人員會(huì)為您解答相關(guān)問題,并提供詳細(xì)的價(jià)格信息。
3.實(shí)地考察:您還可以前往齊魯干細(xì)胞公司實(shí)地考察,與工作人員面對(duì)面交流,了解具體的價(jià)格信息。公司地址:山東省濟(jì)南市歷下區(qū)經(jīng)十路9999號(hào)。
四、結(jié)語
通過以上介紹,相信您對(duì)山東省齊魯干細(xì)胞收費(fèi)標(biāo)準(zhǔn)有了一定的了解。如果您想獲取具體價(jià)格信息,可以通過官方網(wǎng)站、電話咨詢或?qū)嵉乜疾斓榷喾N方式。在選擇干細(xì)胞服務(wù)時(shí),請(qǐng)務(wù)必了解清楚各項(xiàng)費(fèi)用,確保自己的權(quán)益。
- 2024-11-22干細(xì)胞治療脊髓病變費(fèi)用多少,治療周期大概多長(zhǎng)
- 2024-11-27干細(xì)胞治療血栓費(fèi)用多少,治療效果好嗎
- 2024-12-09無錫免疫干細(xì)胞移植費(fèi)用明細(xì),哪家醫(yī)院性價(jià)比高
- 2024-11-05鹽城人體干細(xì)胞治療價(jià)格是多少?如何獲取優(yōu)惠價(jià)格?
- 2024-10-16提取干細(xì)胞生孩子費(fèi)用,安全性與成功率分析?
- 2024-11-01回輸干細(xì)胞價(jià)格一覽:費(fèi)用與效果對(duì)比!
- 2024-09-13人造干細(xì)胞注射費(fèi)用,注射干細(xì)胞需要多少錢
- 2024-09-07干細(xì)胞瘦小腿效果好嗎,干細(xì)胞減肥原理分析
- 2024-10-11青海干細(xì)胞療法費(fèi)用高嗎?與其它地區(qū)相比如何?
- 2024-09-26干細(xì)胞研究現(xiàn)狀如何展開,未來治療潛力有多大
- 2024-10-05南充干細(xì)胞價(jià)格合理嗎?哪里能獲得性價(jià)比高的治療?
- 2024-08-12脂肪干細(xì)胞抗衰老有效果嗎
- 2024-07-29干細(xì)胞醫(yī)療技術(shù),干細(xì)胞療法的副作用大嗎
- 2024-08-07干細(xì)胞治療脊髓損傷,干細(xì)胞修復(fù)脊髓治療費(fèi)用多少
- 2024-10-11造血干細(xì)胞捐獻(xiàn)的意義是什么?如何提高大眾對(duì)其認(rèn)識(shí)?
- 2024-08-02干細(xì)胞療法治療,干細(xì)胞療法可以治療哪些病
- 2024-08-04捐造血干細(xì)胞,捐造血干細(xì)胞是怎么捐的
- 2024-10-07嘉興肝硬化干細(xì)胞功效如何,能否有效改善病情
